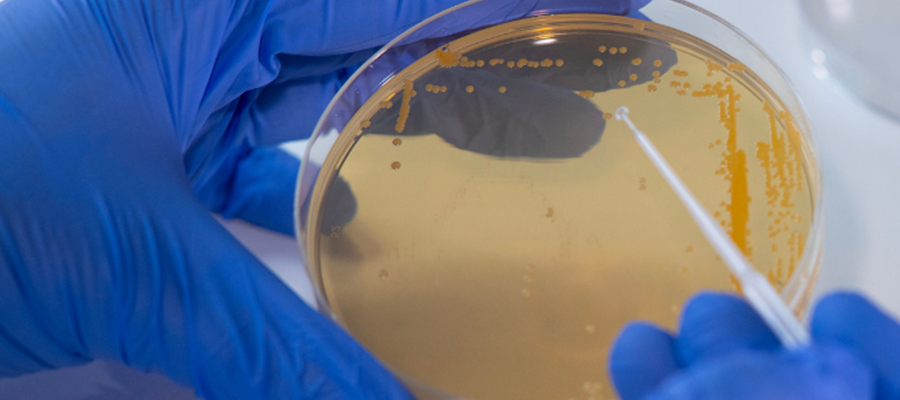

den 14 mars 2025
QureTech Bio beviljas Europapatent för ny klass av antibiotika
Umeåbolaget QureTech Bio AB har beviljats patent av Europeiska patentverket (EPO) för GmPcides, en ny klass av syntetiska antibakteriella läkemedel under utveckling.

Markus Thor
Vd för QureTech Bio.
QureTechs GmPcides representerar en innovativ klass av små molekylära syntetiska antibiotika som effektivt bekämpar läkemedelsresistenta bakterier, inklusive MRSA, utan att visa några tecken på resistensutveckling.
Europapatentet ger patentskydd fram till 2041 och är en viktig milstolpe för Qure Tech Bio. Patentet är sedan tidigare beviljat i Kina och patentansökan är under behandling i USA, Indien och Japan.
"Vi är glada över att ha fått detta patent beviljat av Europeiska patentverket," säger Markus Thor, vd för QureTech Bio.
"Patentet ger ett starkt skydd för GmPcides, vilket är avgörande inom vår bransch, och det markerar ett viktigt steg i att göra våra substanser tillgängliga för patienter som behöver effektiv behandling mot läkemedelsresistenta bakterier."
Den EPO-beviljade patentansökan har titeln "Ringfuserade 2-pyridonföreningar, metoder för deras framställning och deras användning vid behandling och/eller förebyggande av sjukdomar orsakade av grampositiva bakterier".
Källa: Umeå Biotech Incubator (UBI).